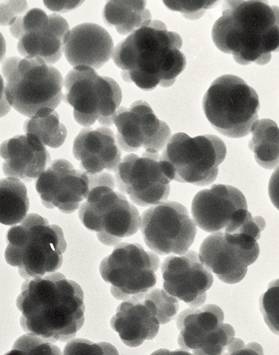

Development of processes to achieve latexes with improved performance
This encompasses several projects aiming at improving the performance of the final product through better processes.
-
Kinetics of Emulsion Polymerization Systems
-
Latex Particle Morphology
-
Latexes with Better Binding Power
-
Reactive Surfactants for High Performance Latexes
-
Miniemulsion Polymerization
-
Polymer microstructure- performance relationships
|
|
Kinetics of EmulsionThis is an on-going project that provides valuable information to many other projects in the lab. Polymerization in dispersed media occurs in a heterogeneous compartmentalized system, and the processes that characterize this system are radical entry and exit. Considerable efforts have been devoted to gain some knowledge on these processes. A new theory for radical exit, better mathematical approaches for accurate estimation of entry and exit rate coefficients, the determination of these parameters for some specific monomers, kinetic studies of high solids multi-monomer systems, the effect of using oil-soluble initiators and the effect of inhibition by oxygen are some of the outputs of this program. Further understanding of particle nucleation and coagulation is the challenge for the next future. |
|
|
|
|
|
Latex Particle MorphologyThe performance of composite latex particles is determined by their morphology, which in turn depends on the interplay of kinetics and thermodynamics. Most of the mathematical models reported for the prediction of the particle morphology consider that the equilibrium morphology is reached, and hence base their predictions on thermodynamic considerations. However, there is plenty of experimental evidence showing that nonequilibrium morphologies are often formed. A mathematical model able to predict the development of the latex particle morphology by taking into account the relevant kinetic and thermodynamic effects has been developed. The model accounts for phase separation leading to cluster nucleation, polymerization, polymer diffusion and cluster migration. The model is validated by comparison with experimental results. Future work includes the combination of this model with strategies for on-line control of particle morphology (see below) and the extension of the model to systems involving grafting and to hybrid latexes. |
|
|
|
Latex with Better Binding PowerBinding power depends on polymer microstructure, and hence it is of paramount importance to understand the mechanisms controlling copolymer composition, MWD of the sol fraction, branching and gel fraction. Acrylic latexes have been chosen as a relevant example. The effect of operation conditions and presence of comonomers and CTA on the kinetics of emulsion polymerization of butyl acrylate is investigated. Extensive intramolecular chain transfer to polymer (backbiting) gives a large number of short chain branches. The tertiary radicals formed in this mechanism have low reactivity, and this leads to a reduction of the apparent propagation rate constant. Another consequence is that the propagation rate constant value determined by pulsed laser polymerization (PLP) in bulk conditions cannot be used in starved emulsion polymerization. Intermolecular chain transfer is much less frequent that backbiting, but, together with bimolecular termination by combination, determines the gel fraction. The relationships between sol MWD and gel fraction as well as those between polymer microstructure and product properties are studied. A mathematical model for the process was developed. The study was also extended to other acrylic monomers like 2EHA. Future research will be focused on the understanding of the mechanisms controlling polymer microstructure in the presence of crosslinking agents, and on the use of this knowledge to develop on-line control strategies (see below). |
|
|
|
|
|
|
Reactive Surfactants for High Performance LatexesSurfactants play a crucial role in the production of emulsion polymers, but they can also have adverse effects during application. For example, when the latex is coated at high application rates or mixed with pigments in paints, the surfactant may desorb from the polymer particle causing destabilization. The surfactant can also have adverse effects on gloss and adhesion. These drawbacks are due to the mobility of the surfactant. Therefore, a promising way to reduce the negative effects of the surfactant is to use polymerizable surfactants (surfmers). Extensive work has been out in our lab to achieve a high degree of incorporation of the surfmer into the polymer avoiding surfmer burying inside the polymer particles. Analytical methods for determination of the unreacted surfmer and surfactant migration during film formation, mathematical models for emulsion polymerization using surfmers, as well as the development of strategies for optimal usage of reactive surfactants have been developed. Future work will involve efforts to a priori determine the ideal surfmer structure for each particular emulsion polymerization system. |
|
|
|
|
|
Miniemulsion PolymerizationMiniemulsions are finely divided oil-in-water dispersions stabilized against coagulation by conventional emulsifiers and containing a highly water-insoluble compound (hydrophobe) to minimize the Oswald ripening effect. Monomer miniemulsions can be polymerized upon addition of either water-soluble or oil-soluble initiators leading to a dispersed polymer, somehow similar to a latex produced by conventional emulsion polymerization. The main difference is that in miniemulsion polymerization, particle nucleation occurs by radical entry in submicron monomer droplets. This feature is advantageously used to incorporate highly water-insoluble compounds to the polymer, to produce highly concentrated latexes of reduced viscosity and to achieve stable operations in CSTRs. Future work will focus on both the investigation of key parameters necessary to up-scale miniemulsion processes and on the development of novel and smart materials (see below). |
|
|
|
|
|
Polymer microstructure- performance relationshipsAdhesion properties (tack, peel, and shear) depend on MWD in a way in which improvements in one property many times results in a deterioration of the other properties. Well-balanced products are often obtained through trial and error. Quantitative polymer microstructure- performance relationships have been developed in order to design the best MWD for a particular application. The process strategy relies on the technology developed in our lab for producing MWDs of any shape and on the intensive use of chemometrics. Future research will address further use of chemometrics to interpret the process conditions to end-use properties relationship. |